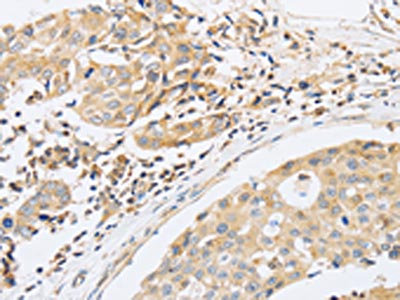

-
中文名稱:ABHD5兔多克隆抗體
-
貨號:CSB-PA149552
-
規格:¥1100
-
圖片:
-
其他:
產品詳情
-
Uniprot No.:
-
基因名:
-
別名:1-acylglycerol-3-phosphate O-acyltransferase ABHD5 antibody; ABHD5 antibody; ABHD5_HUMAN antibody; Abhydrolase domain containing 5 antibody; Abhydrolase domain containing protein 5 antibody; Abhydrolase domain-containing protein 5 antibody; CDS antibody; CGI 58 antibody; CGI58 antibody; CGI58 protein antibody; IECN2 antibody; Lipid droplet-binding protein CGI-58 antibody; MGC8731 antibody; NCIE2 antibody
-
宿主:Rabbit
-
反應種屬:Human,Mouse,Rat
-
免疫原:Fusion protein of Human ABHD5
-
免疫原種屬:Homo sapiens (Human)
-
標記方式:Non-conjugated
-
抗體亞型:IgG
-
純化方式:Antigen affinity purification
-
濃度:It differs from different batches. Please contact us to confirm it.
-
保存緩沖液:-20°C, pH7.4 PBS, 0.05% NaN3, 40% Glycerol
-
產品提供形式:Liquid
-
應用范圍:ELISA,IHC
-
推薦稀釋比:
Application Recommended Dilution ELISA 1:1000-1:2000 IHC 1:15-1:50 -
Protocols:
-
儲存條件:Upon receipt, store at -20°C or -80°C. Avoid repeated freeze.
-
貨期:Basically, we can dispatch the products out in 1-3 working days after receiving your orders. Delivery time maybe differs from different purchasing way or location, please kindly consult your local distributors for specific delivery time.
-
用途:For Research Use Only. Not for use in diagnostic or therapeutic procedures.
相關產品
靶點詳情
-
功能:Coenzyme A-dependent lysophosphatidic acid acyltransferase that catalyzes the transfert of an acyl group on a lysophosphatidic acid. Functions preferentially with 1-oleoyl-lysophosphatidic acid followed by 1-palmitoyl-lysophosphatidic acid, 1-stearoyl-lysophosphatidic acid and 1-arachidonoyl-lysophosphatidic acid as lipid acceptor. Functions preferentially with arachidonoyl-CoA followed by oleoyl-CoA as acyl group donors. Functions in phosphatidic acid biosynthesis. May regulate the cellular storage of triacylglycerol through activation of the phospholipase PNPLA2. Involved in keratinocyte differentiation. Regulates lipid droplet fusion.
-
基因功能參考文獻:
- our findings indicate that inhibition of both DGAT1 and ABHD5 using siRNA leads to reduction in prostate cancer cell growth. PMID: 28877685
- Prebinding CGI-58 with PI(3)P or PI(5)P did not alter its coactivation of ATGL in vitro. In summary, purified recombinant CGI-58 that is functional as an ATGL coactivator lacks LPAAT activity. PMID: 24879803
- It is clear that CGI-58 can regulate TAG hydrolysis by activating the major TAG hydrolase adipose triglyceride lipase (ATGL), yet CGI-58 can also regulate lipid metabolism via mechanisms that do not involve ATGL. PMID: 28827091
- ABHD5 possesses a PNPLA2-independent function in regulating autophagy and tumorigenesis. PMID: 27559856
- These results indicate that HCV taps into the lipid droplet triglyceride reservoir usurping ABHD5 lipase cofactor function PMID: 27124600
- Case Report: novel ABHD5 mutation, c.838C > T (p.Arg280*), in trans with p.Arg234* in a Chinese patient with very mild Dorfman-Chanarin syndrome. PMID: 26547112
- Authors show that rat ATGL, coactivated by rat CGI-58, efficiently hydrolyzes triglycerides and retinyl ester. PMID: 26330055
- novel ABHD5 truncating variant in a twenty nine month old female child, who presented with icthyosiform erythroderma. PMID: 26353074
- simultaneous tryptophan alanine permutations in both arms abolish localization and activity of CGI-58 as opposed to tryptophan substitutions that occur in only one arm. PMID: 26350461
- this study presents clinical and molecular data of four affected relatives with Chanarin-Dorfman syndrome homozygous for a N209X mutation in ABHD5, and provides a short review by comparing patients with N209X homozygous mutations to patients with other ABHD5 mutations. PMID: 25682902
- PLIN5 was significantly colocated with ATGL, mitochondria and CGI-58, indicating a close association between the key lipolytic effectors in resting skeletal muscle. PMID: 25054327
- -mediated phosphorylation of CGI-58 is required for dispersion of CGI-58 from perilipin 1A-coated lipid droplets PMID: 25421061
- Abhd5 expression falls substantially and correlates negatively with malignant features in human colorectal cancer. PMID: 25482557
- Findings indicate a molecular mechanisms by which lysophosphatidic acid acyltransferase CGI-58 regulates lipid homeostasis. PMID: 25315780
- A report of two Chanarin-Dorfman syndrome sisters with severe steatohepatitis and decompensated cirrhosis due to steatohepatitis in whom the clinical presentation developed due to a new mutation in ABHD5 gene. PMID: 22245374
- an important metabolic function of CGI-58 in skeletal muscle PMID: 22383684
- A novel nonsense mutation of ABHD5 is reported in a consanguineous Afgani family with 4 sibs with Dorfman Chanarin syndrome; the mutation leads to protein truncation by 14 AAs; findings include liver cirrhosis, corneal opacities,tessellated fundus PMID: 22373837
- the C terminus sequesters ABHD5 and thus inhibits basal ATGL activity PMID: 21757733
- First report of large genomic deletions in the ABHD5 gene in Chanarin-Dorfman syndrome patients from Mediterranean countries. PMID: 21122093
- analysis of novel mutations in the ABHD5 gene in Chanarin-Dorfman syndrome (CDS) patients PMID: 20307695
- CGI-58 not only facilitates triglyceride lipolysis, but also provides fatty acid for esterification of ceremide leading to acylceremides PMID: 20520629
- ABDH5 gene mutation is found in patients diagnosed with Chanarin Dorfman syndrome. PMID: 15967942
- CGI-58 interacts with adipose triglyceride lipase, stimulating its TG hydrolase activity up to 20-fold PMID: 16679289
- CGI-58 facilitates lipolysis in cooperation with perilipin and other factors, including lipases PMID: 17308334
- analysis of a novel S115G mutation of CGI-58 in a Turkish patient with Dorfman-Chanarin syndrome [case report] PMID: 17495960
- Deficient in lipid storage diseases. PMID: 17631826
- These data enriches the list of CGI-58 mutations associated with Chanarin-Dorfman syndrome and confirms the clinical and allelic heterogeneity of this disease, especially the inconsistent muscle involvement. PMID: 18339307
- CGI-58, the causative gene for Chanarin-Dorfman syndrome, mediates acylation of lysophosphatidic acid PMID: 18606822
- CGI-58 is expressed and packaged into lamellar granules (LG) during keratinization and likely plays crucial role(s) in keratinocyte differentiation and LG lipid metabolism, contributing to skin lipid barrier formation. PMID: 18832586
- Chanarin-Dorfman syndrome: deficiency in CGI-58, a lipid droplet-bound coactivator of lipase. (Review) PMID: 19061969
- review summarizes recent findings with the goal of relating structural variants of ATGL and CGI-58 to functional consequences in lipid metabolism [review] PMID: 19401457
- mutational analysis in Chanarin-Dorfman syndrome PMID: 11590543
顯示更多
收起更多
-
相關疾病:Chanarin-Dorfman syndrome (CDS)
-
亞細胞定位:Cytoplasm. Lipid droplet. Cytoplasm, cytosol.
-
蛋白家族:Peptidase S33 family, ABHD4/ABHD5 subfamily
-
組織特異性:Widely expressed in various tissues, including lymphocytes, liver, skeletal muscle and brain. Expressed by upper epidermal layers and dermal fibroblasts in skin, hepatocytes and neurons (at protein level).
-
數據庫鏈接:
Most popular with customers
-
YWHAB Recombinant Monoclonal Antibody
Applications: ELISA, WB, IHC, IF, FC
Species Reactivity: Human, Mouse, Rat
-
Phospho-YAP1 (S127) Recombinant Monoclonal Antibody
Applications: ELISA, WB, IHC
Species Reactivity: Human
-
-
-
-
-
-